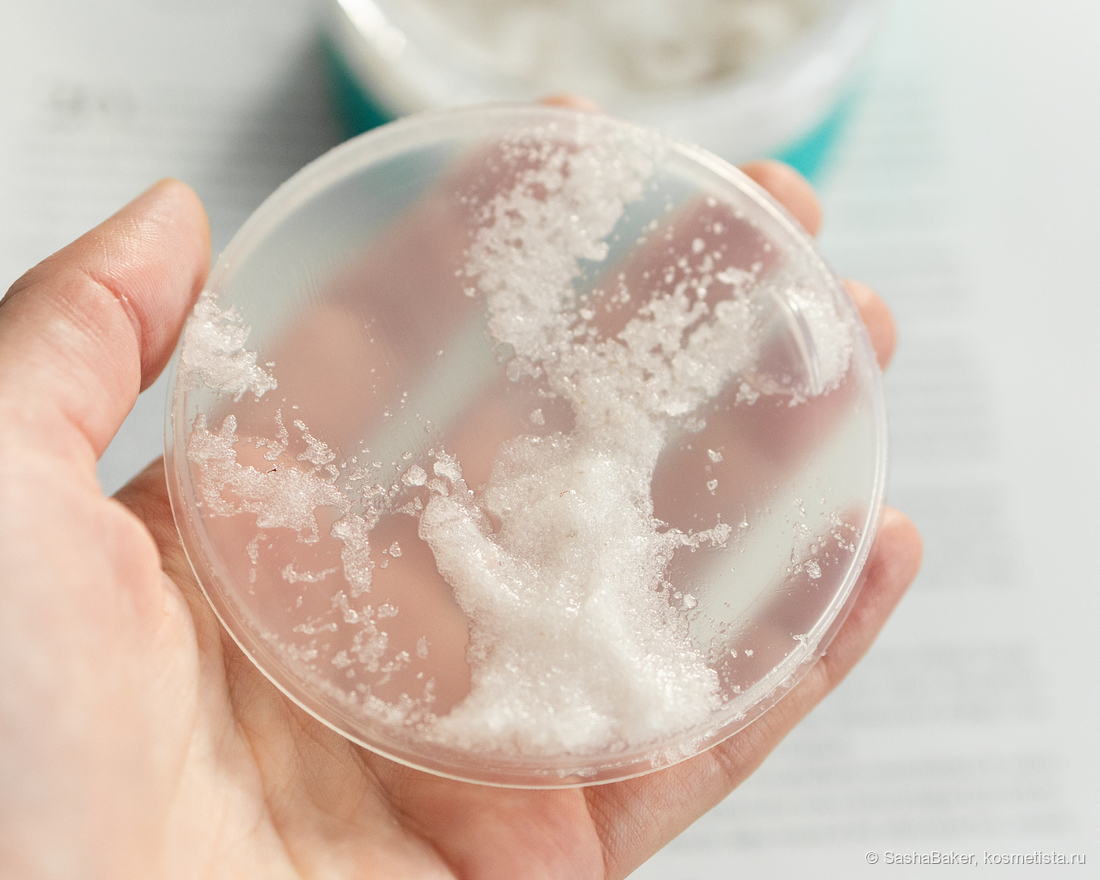

Непопулярное мнение или почему я покупаю Letique снова и снова?
Сегодня рассмотрим:
- Letique Cosmetics Скраб Для Тела Вишня
- Letique Cosmetics Баттер Для Тела Барбадосская Вишня

Когда бренд создан блогером с противоречивой репутацией, ожидания закономерно сводятся к нулю. Здесь же именно тот случай, где предубеждения рискуют перевесить суть. Но вопреки общественному мнению, продукты по уходу за телом от бренда стали для меня мастхевом.

Letique Cosmetics Скраб Для Тела Вишня, 250g.
Оформление в духе бренда, для своей цены вполне качественная упаковка, присутствует пластиковый вкладыш, что бы не попадала вода/ средство не засыхало, если в спешке на свидание не плотно закрутили крышку.

Сзади есть наклейка с необходимой информацией о средстве. Там и способ применения указан, правда на несколько минут скраб на теле я не оставляю, вечно куда то спешу.
Состав тоже указан, много приятного — масло вишнёвых косточек, бутоны вереска розового, масло миндаля, витамин Е, масло ши. Всё это способно поухаживать за нашей кожей. Причём каких-то вредных ингридиентов замечено не было.

Солевой скраб для тела с текстурой средней жёсткости, напоминающей мелкий песок и тающую карамель, плотный, но не царапает, главное, наносить его на влажную кожу тела, он полирует её, кожа мягкая, увлажнённая и напитанная, не оставляет ощущения стянутости, наоборот после того, как смываю скраб — ощущаю масла на теле, могу вполне себе не пользоваться кремом после. Это одно из моих любимых ощущений после применения скрабов этой марки.

Аромат безумный. Я могу сравнить его с жвачкой со вкусом вишни от Eclipse. Он такой же яркий и насыщенный, при использовании скраба — аромат в ванной комнате витает повсюду. Мне очень нравится такая ароматерапия именно в осенне-зимний период, когда повсюду серость и хандра.




Использую скраб два раза в неделю, расход умеренный, просто я его совсем не берегу. За свою стоимость отличный продукт, покупаю и буду покупать. Если вы любите насыщенные ароматы в средствах по уходу за телом — это ваша остановочка. Попробуйте.
Оценка 5/5
Срок использования — несколько лет
Стоимость — 500Р (со скидкой).
Letique Cosmetics Баттер Для Тела Барбадосская Вишня, 200ml.

Баттер-крем по текстуре напоминает взбитый зефир, который на коже превращается в молочко. Он не ложится плёнкой, не липнет к одежде и впитывается за секунды, что для плотного баттера — редкое качество.
В составе есть три масла для питания и смягчения, витамин С, а так же экстракт барбадосской вишни для тонуса и антиоксидантной защиты. Масло вишнёвых косточек дополняет комплекс, укрепляя гидролипидный барьер и ускоряя восстановление кожи.



Аромат. Это точная копия йогурта Fruttis с вишней (я его обожаю) — с лёгкой кислинкой, сладостью и молочными нотами. Он яркий и стойко сопровождает несколько часов уже после применения.

После использования баттера кожа очень мягкая и тактильно приятная, нежная. Это то, что я ищу в уходе за телом, что бы без всяких но. Лучшие использовать средства в холодный период времени, для лета может показаться тяжеловатым, зато сейчас — самое время.

Люблю эти средства в совокупности и по отдельности, другие ароматы мне тоже очень нравятся. Так переодически все по кругу меняю, что бы не успело надоесть. Рекомендую попробовать, как минимум, средства по уходу за телом, они заслуживают шанса, вне зависимости от того, кто их создал.
Оценка 5/5
Срок использования — несколько лет
Стоимость — 550Р ( со скидкой)
Комментарии
Мне все вкусы нравятся))